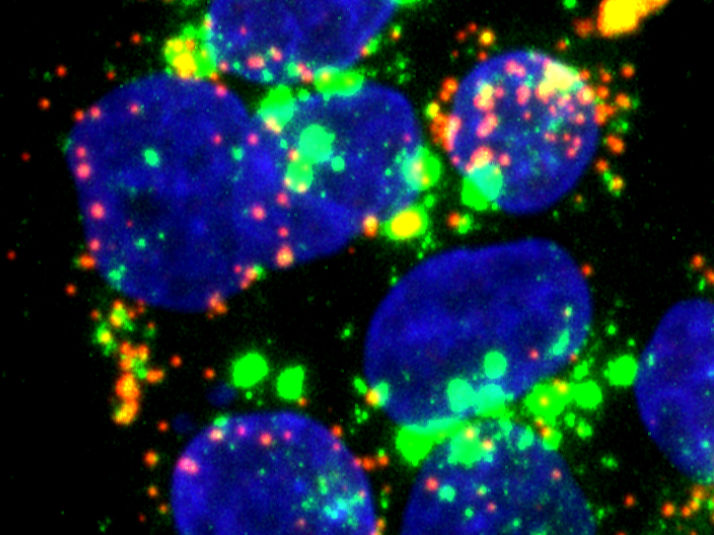
© Molekulare und Medizinische Virologie

Neuer zellulärer Angriffspunkt verhindert Hepatitis-E-Infektion
Statt das Virus direkt anzugreifen, setzt die Verbindung bei der Wirtszelle an und verhindert die Infektion
Anzeigen
Ein internationales Forschungsteam hat einen vielversprechenden neuen Ansatz zur Behandlung von Infektionen mit dem Hepatitis-E-Virus (HEV) identifiziert. Im Zentrum der Studie steht der Wirkstoff Apilimod, der gezielt den Eintritt des Virus in menschliche Leberzellen blockiert und damit eine Infektion bereits in einem frühen Stadium unterbindet. Der Wirkstoff richtet sich gegen einen Mechanismus der Wirtszelle, sodass die Wahrscheinlichkeit sinkt, dass das Virus dagegen Resistenzen entwickelt. Apilimod ist bereits klinisch untersucht. Das könnte seine Weiterentwicklung zu einem Medikament gegen Hepatitis E beschleunigen. Die Studie, an der die Abteilung Molekulare und Medizinische Virologie der Ruhr-Universität Bochum beteiligt ist, ist in der Zeitschrift eGastroenterology vom 31. März 2026 veröffentlicht.
Immunfluoreszenzbilder des HEV-Eintritts: Hepatitis-E-Virus-RNA (rot), endolysosomale Kompartimente (grün) und Zellkerne (blau).
© Molekulare und Medizinische Virologie
Ein unabdingbares Enzym
Um sich zu vermehren, muss ein Virus zunächst in eine Wirtszelle eindringen. Genau an diesem Punkt setzt die Studie an: Die Forschenden untersuchten gezielt Prozesse der Wirtszellen, die HEV für eine erfolgreiche Infektion benötigt. Dabei identifizierten sie das Enzym PIKfyve als entscheidenden Faktor für den Viruseintritt. PIKfyve spielt eine zentrale Rolle in intrazellulären Transportprozessen, insbesondere im endolysosomalen System – einem Netzwerk von Zellkompartimenten, das von vielen Viren als Eintrittsweg genutzt wird.
In ihren Experimenten identifizierten die Forschenden den PIKfyve-Inhibitor Apilimod als besonders wirksam. Der Wirkstoff verhinderte effizient das Eindringen des Virus in die Zellen. Im Gegensatz zu klassischen antiviralen Substanzen greift Apilimod nicht direkt das Virus an, sondern blockiert einen zellulären Mechanismus, den das Virus für sich nutzt. „Das ist ein entscheidender Vorteil“, sagt Koautorin Sarah Schlienkamp. „Da wir auf einen Wirtsfaktor abzielen, ist die Wahrscheinlichkeit geringer, dass das Virus Resistenzen entwickelt“, ergänzt Koautor Julian Ring.
Sicherer und verträglicher Wirkstoff
Die Wirksamkeit von Apilimod wurde in verschiedenen Modellsystemen bestätigt – darunter Zellkulturen, primäre menschliche Leberzellen sowie ein Tiermodell mit infizierten Ratten. In allen Versuchen konnte die Viruslast deutlich reduziert werden.
„Besonders interessant ist, dass Apilimod bereits klinisch untersucht wurde und ein bekanntes Sicherheitsprofil besitzt“, betont Koautorin Maria Darido. „Das könnte die Weiterentwicklung für die Behandlung von Hepatitis E erheblich beschleunigen.“
Darüber hinaus zeigen die Ergebnisse, dass die Hemmung von PIKfyve gezielt den Viruseintritt unterbindet, ohne zentrale Zellfunktionen wesentlich zu beeinträchtigen. Dies spricht für eine potenziell gute Verträglichkeit – ein wichtiger Aspekt für zukünftige klinische Anwendungen.
Insgesamt unterstreichen die Befunde das Potenzial von Therapien, die gegen Wirtsfaktoren gerichtet sind. Statt das Virus selbst anzugreifen, zielen diese Strategien auf zelluläre Prozesse ab, die für die Virusinfektion essenziell sind. Dadurch könnten sie auch gegenüber neu auftretenden Virusvarianten wirksam bleiben.
Künftige Studien müssen nun klären, inwieweit sich die vielversprechenden Ergebnisse in klinische Anwendungen übertragen lassen.
Originalveröffentlichung
Julian J Ring, Sarah Schlienkamp, Maria L Goussain Darido, Xin Zhang, Olinda Pinto Veiga, Jil Alexandra Haase, Emely Richter, André Gömer, Rebecca Menhua Fu, Viet Loan Dao Thi, Rainer G Ulrich, Mara Klöhn, Daniel Todt, Verian Bader, Konstanze F Winklhofer, Volker Kinast, Johan Neyts, Suzanne J F Kaptein, Eike Steinmann, Yannick Brüggemann; "Phosphoinositide kinase PIKfyve inhibitor apilimod blocks hepatitis E virus infection"; eGastroenterology, Volume 4, 2026-3-31




























































